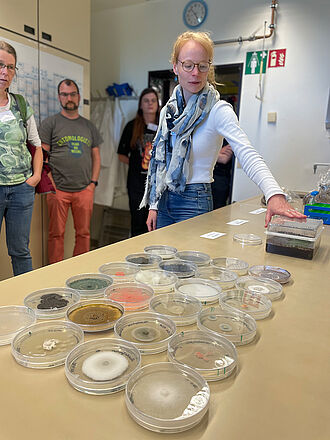
Das Teilprojekt umfasst die Untersuchung und Bestimmung von Pilzen und Oomyceten in Kultursubstratausgangsstoffen.

Am 12. und 13. Mai fand am JKI-Standort Braunschweig Messeweg das zweite Projekttreffen und erste Beiratstreffen des Verbundvorhabens (Torfreduktion mit sicheren Substraten für den professionellen Gartenbau) statt. Das Projekt ToSuGa wird von Dr. Ute Vogler geleitet, die Projektkoordination übernimmt Dr. Annmarie-Deetja Rohr vom Institut G.
Hintergrund
Das Vorläuferprojekt ToPGa (Entwicklung und Bewertung von torfreduzierten Produktionssystemen im Gartenbau) hat sich erfolgreich den Herausforderungen bei der Erforschung und Bewertung torfreduzierter Kultursubstrate gestellt – mit einem Fokus auf ganzheitliche Betrachtung und Bewertung im professionellen Gartenbau.ToSuGa baut nun auf diesen Erkenntnissen auf, um praxisrelevante Empfehlungen für sichere Substrate in den verschiedenen Sparten des professionellen Gartenbaus zu entwickeln. Damit leistet das Projekt einen wichtigen Beitrag zur Nachhaltigkeit im Gartenbau. In den Teilprojekten sollen gemeinsam mit den Verbundprojektpartnern verschiedene Aspekte zur Gewährleistung der Kultursubstratsicherheit näher erforscht werden.